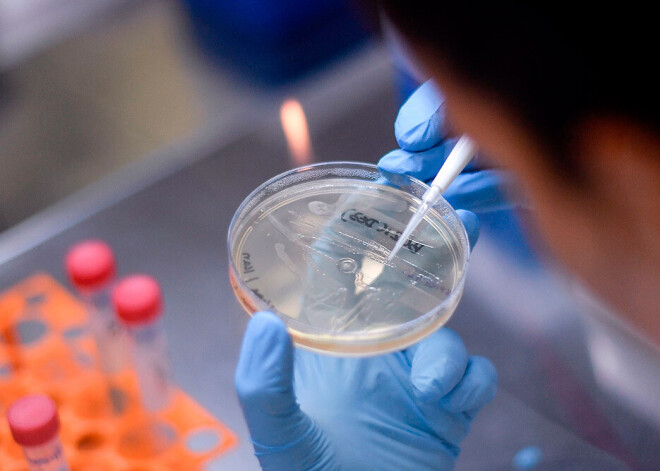

ES pieņem regulējumu, lai paātrinātu Covid-19 vakcīnas izstrādi
Eiropas Savienība (ES) otrdien pieņēma regulējumu, kura mērķis ir paātrināt vakcīnas izstrādi pret jauno koronavīrusu.
ES Padome paziņoja, ka šis regulējums nozīmē to, ka vakcīnas klīniskajiem izmēģinājumiem vairs nebūs jāveic vides risku novērtējumi attiecībā uz ģenētiski modificētu organismu (ĢMO) izlaišanu un izmantošanu.
Šis likumdošanas akts, kas stāsies spēkā sestdien, arī ļauj dalībvalstīm atļaut ĢMO saturošu medicīnas produktu izmantošanu Covid-19 ārstēšanai vai novēršanai.
Vācijas veselības ministrs Jenss Špāns sacīja, ka šis "regulējums nodrošinās to, ka klīniskie izmēģinājumi ES var sākties bez aizkavēšanās un netiks zaudēts vērtīgais laiks", jo Covid-19 vakcīna ir steidzami nepieciešama.
ES regulējums attiecas uz laika posmu, kurā Pasaules Veselības organizācija (PVO) definējusi Covid-19 uzliesmojumu kā pandēmiju, vai uz laiku, kamēr Eiropas Komisija identificē situāciju kā veselības krīzi, kuru izraisījusi Covid-19.